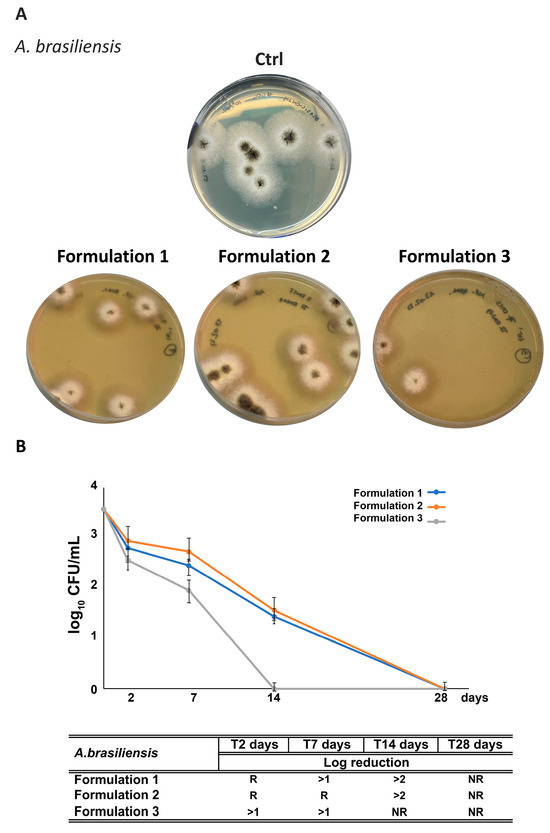

Abstract
Roasted hazelnut skins (RHSs), generated as by-products of industrial hazelnut processing, were extracted by pressurized liquid extraction to yield a hydroalcoholic extract (RHS-H). The extract was rich in polyphenols (308.4 ± 4.6 mg GAE/g) and proanthocyanidins (169.3 ± 10 mg CE/g) and showed strong antioxidant activity (DPPH EC50 = 5.08 ± 1.08 µg/mL; TEAC = 2.82 ± 0.03 mM Trolox/mg) together with antimicrobial effects against Staphylococcus aureus and Staphylococcus epidermidis. RHS-H also enhanced the UV absorbance of synthetic UV filters. When incorporated into oil-in-water (O/W) cosmetic emulsions at low concentrations (0.2–2% w/w), RHS-H did not affect physicochemical stability: formulations maintained acceptable organoleptic properties, dermocompatible pH (4.7–5.5), electrostatic stability (ζ-potential ranging from –57 to –60 mV), and rheological behavior. Functionally, RHS-H increased the antioxidant activity of emulsions (radical scavenging > 80% vs. 52% in the blank), ensured microbial protection in challenge tests, and enhanced SPF by 9.4% at 0.2% w/w, with further improvements at higher concentrations, reaching broad-spectrum photoprotection (critical wavelength > 370 nm). Overall, RHS-H represents a natural multifunctional ingredient with antioxidant, preservative, and photoprotective properties, providing a sustainable strategy to upcycle hazelnut processing waste and reduce reliance on synthetic additives in cosmetic formulations.
1. Introduction
Hazelnut (Corylus avellana L.) seed skin accounts for approximately 2.5% of the total nut weight. This brown outer layer is typically discarded during the production of peeled whole or ground roasted hazelnuts, which are widely used in the confectionery industry. While the skin constitutes a minor portion of each nut, large-scale processing generates substantial quantities of this by-product. These skins are mainly destined for landfill or, in some cases, repurposed for animal feed or energy production. However, hazelnut skin is a rich source of bioactive compounds, particularly polyphenols such as oligomeric proanthocyanidins [1,2,3], known for their strong antioxidant properties [4,5]. The polyphenolic profile of roasted hazelnut skin extracts, previously characterized by our group [1], revealed catechin, epicatechin, and galloylated derivatives as major constituents, supporting its potential as a source of biologically active metabolites. The valorization of hazelnut skin aligns with sustainability and circular economy principles by reducing waste and enabling high-value applications from agricultural residues. The recovery of bioactive metabolites from agri-food by-product also addresses the growing demand for sustainable and effective ingredients in skincare formulations. Although European legislation [6] ensures consumer safety regarding cosmetic raw materials, several ingredient classes remain controversial. These include synthetic preservatives (e.g., methylparaben, propylparaben) and organic UV filters (e.g., benzophenone-3, cinnamates, octocrylene, avobenzone), which are associated with potential health risks and environmental toxicity. Reported effects include allergic dermatitis, skin sensitization, estrogenic activity, disruption of male reproductive functions, endocrine interference, and even carcinogenicity. In addition, their persistence in the environment contributes to marine pollution, aquatic toxicity, and coral reef bleaching [7,8]. Despite these concerns, such ingredients remain essential for protecting cosmetic formulations against microbial contamination and for shielding human skin from oxidative damage caused by ultraviolet (UV) radiation and reactive oxygen species (ROS). Microbial growth in water-containing cosmetics can alter sensory characteristics, degrade functional ingredients, and cause skin irritation or inflammation. Meanwhile, overexposure to UVB (280–320 nm) and UVA (320–400 nm) radiation accelerates skin aging, dryness, and the onset of skin cancers such as melanoma. UV-induced ROS generation damages epidermal and dermal cell DNA. Although ROS have physiological roles in cell signaling and defense, their overproduction, especially due to UV exposure, disrupts redox homeostasis and triggers oxidative stress, a major contributor to photoaging [9,10]. While the skin deploys endogenous antioxidants (e.g., glutathione, glutathione peroxidase, catalase, ubiquinol), these defenses decline with age. Therefore, topical supplementation with natural antioxidants may offer protective benefits [11]. Synthetic organic filters and antioxidant agents in cosmetic formulations can absorb harmful UV radiation and mitigate oxidative damage [12,13]. However, due to rising safety and ecological concerns, regulatory bodies may impose concentration limits or full bans on these ingredients. As a result, raw material suppliers are actively seeking natural alternatives that meet both efficacy and safety expectations [14,15]. Among promising candidates are polyphenols, multifunctional natural compounds that help plants withstand abiotic stressors like UV radiation by scavenging ROS and absorbing short-wavelength light [16]. These properties make polyphenol-rich extracts from agri-food by-products particularly attractive for cosmetic applications [17,18]. Such extracts offer dual functionality: they both support skin health by countering oxidative stress, inflammation, and cellular senescence, and enhance product safety by inhibiting microbial growth during shelf life and consumer use [7,19,20].
This study investigates the potential of a roasted hazelnut skin hydroalcoholic extract (RHS-H), obtained via a green extraction process, as a sustainable multifunctional ingredient for cosmetic use. The research includes an evaluation of its antioxidant activity and antimicrobial properties, as well as the assessment of its ability to enhance the efficacy of synthetic organic UV filters. Furthermore, RHS-H was incorporated into oil-in-water (O/W) emulsions, which were analyzed for physicochemical stability, antioxidant performance, microbiological protection, and photoprotective enhancement.
2. Materials and Methods
2.1. Chemicals, Reagents, and Microorganisms
Analytical-grade ethanol, Folin–Ciocalteu reagent, sodium carbonate (Na2CO3), gallic acid, 1,1-diphenyl-2-picrylhydrazyl radical (DPPH), (+)-catechin, 2,2′-Azino-bis(3-ethylbenzothiazoline-6-sulfonic acid) (ABTS), potassium persulfate, PBS, Propylene Glycol, vanillin, benzyl mercaptan and Trolox were purchased from Merck KGaA (Darmstadt, Germany). Glycerin, Xanthan Gum, Disodium Ethylenediaminetetraacetic acid (EDTA), Butirrospermum Parkii, Cetearyl Alcohol, Ethylhexyl Stearate, Persea Gratissima Oil, Dimethicone, Caprylic/Capric Triglyceride, Dicapryl Ether, C12-15 Alkyl Benzoate, Ethylhexyl Methoxycinnamate, Butyl Methoxydibenzoylmethane, Octocrylene, Butyl Hydroxytoluene were acquired from A.C.E.F. S.p.A. (Fiorenzuola d’Arda, PC, Italy). Phenoxyethanol (and) Ethylhexylglycerin was purchased from Thor Especialidades, S.A. (Castellgalí, Barcelona, Spain), and Glyceryl Stearate (and) Peg-100 Stearate from BASF (Ludwigshafen, Germany).
2.2. Hazelnut Skin Biomass and Extraction Procedure
Roasted hazelnut skins (RHS), obtained as industrial by-products from a processing company in Avellino (Campania, Italy), were milled and sieved to obtain a particle size fraction of 300–600 µm. The extract (RHS-H) was prepared using pressurized liquid extraction (PLE) with aqueous ethanol (30%, v/v) under previously described conditions [21]. Briefly, the extraction was carried out with five cycles at 125 °C and 1500 psi, and the solvent was subsequently removed at 40 °C under reduced pressure by a rotary evaporator (Heidolph Hei-VAP Value Digital, Schwabach, Germany), followed by lyophilization by a freeze dryer Alpha 1–2 LD (Christ, Osterode am Harz, Germany). The extraction yield was determined gravimetrically and was 33.2 g per 100 g of dry material.
2.3. Hazelnut Skin Hydroalcoholic Extract (RHS-H) Characterization
2.3.1. Total Phenolic Content
The polyphenolic content of RHS-H was quantified using the Folin–Ciocalteu colorimetric assay as reported by Piccinelli et al. 2016 [1] with some modifications. Gallic acid served as a calibration standard. Gallic acid served as a calibration standard curve (y = 0.0207x − 0.4233, R2 = 0.9968, concentration range 20–75 μg /mL), and results were expressed as mg of gallic acid equivalents (GAE) per gram of extract.
50 µL of a 1:10 dilution of RHS-H (100 µg/mL) with H2O was added to 450 µL of Folin’s reagent. After 3 min, 500 µL of a 10% solution of sodium carbonate (Na2CO3) were added. The samples were incubated in the dark for 1 h and the absorbances were evaluated with a spectrophotometer (Analytic Jena Specord 200 plus, Konrad-Zuse-Straße, Leer, Germany) at λ 723 nm.
2.3.2. Determination of Total Proanthocyanidin (Pas) Content (Vanillic Assay)
For determination of PAs content, the vanillin assay was employed as reported by Butler et al. 1982 [22] with some modifications. In brief, 40 μL of RHS-H (200 μg/mL in acetic acid) were mixed with 200 μL of vanillin solution (0.5% vanillin reagent, w/v, in acetic acid, plus 4% of concentrated HCl) in a 96-well microplate. After 5 min at room temperature, absorbance was read at 510 nm using a microplate spectrophotometer reader Multiskan Go (ThermoFisher Scientific, Milan, Italy). A control without vanillin reagent and a blank with acetic acid instead of the sample were included in the assay. The concentration of total PAs was estimated from a calibration curve using catechin (range 1–100 μg/mL, prepared in acetic acid) and the data were expressed as catechin equivalent (CE mg/ g extract, means ± S.D. of three determinations).
2.3.3. Thiolysis
An acid-catalyzed depolymerisation in the presence of benzyl mercaptan as nucleophilic reagent (thiolysis), coupled to HPLC-UV-HRMS analysis, was applied to determine the nature and the proportion of the flavanol units and average Degree of Polymerization (mDP) of PA mixtures [23]. The thiolysis reaction was carried out following the method described by Piccinelli et al. 2016 [1], with no substantial modifications. Briefly, the reaction was initiated by adding 50 μL acidified methanol (HCl, 3.3%, v/v) and 100 μL of benzyl mercaptan solution (5%, v/v, in methanol) to 50 μL of the extract (4 mg/mL in methanol). After 30 min at 40 °C, 200 μL of water were added to the reaction mixture and the samples were analyzed by HPLC-UV analysis using the same conditions reported in Piccinelli et al. 2016 [1]. Experiments were performed in triplicate.
2.3.4. Bleaching of the Radical 1,1-Diphenyl-2-picrylhydrazyl (DPPH Test)
The antioxidant potential was evaluated through the reduction of the stable DPPH radical, according to Esposito et al. 2019 [24] with slight modifications. The effective concentration at 50% inhibition (EC50) was determined, corresponding to the sample concentration required to quench half of the radical population. The concentration of DPPH in the reaction medium was calculated from a calibration curve (y = 0.0211x + 0.0380, R2 = 0.9975, range = 5–36 µg/mL). To 1.5 mL of a methanolic solution of DPPH (3.6 mg/100 mL) prepared daily, 37.5 μL of RHS-H (from 6.25 to 50 μg/mL) or positive control (catechin, from 5 to 20 μg/mL) were added. All tests were performed in triplicate.
2.3.5. Trolox Equivalent Antioxidant Capacity (TEAC) Assay
The antioxidant activity of RHS-H was further evaluated by the ABTS·+ radical cation decolorization method, following Esposito et al. 2019 [24] with minor modifications. The ABTS·+ radical was generated by mixing 7.0 mM ABTS with 2.45 mM potassium persulfate (1:1, v/v) and allowing the solution to react overnight in the dark at room temperature. The resulting radical stock was diluted with PBS (pH 7.4) to obtain a working solution with an absorbance of 0.70 ± 0.05 at 734 nm. For the assay, 15 µL of RHS-H (0.005125–0.001 mg/mL) or catechin standard (0.003–0.0075 mM) were added to 1485 µL of the ABTS·+ working solution. After 1 min of incubation at room temperature, absorbance was recorded at 734 nm using a Thermo Evolution 201 UV–vis spectrophotometer (Thermo Fisher Scientific, Milan, Italy). PBS without ABTS·+ served as the blank. Antioxidant capacity was expressed as Trolox Equivalent Antioxidant Capacity (TEAC, mmol Trolox/mg extract or mmol compound), calculated from a Trolox calibration curve.
2.3.6. UV Spectra and In Vitro Sun Protection Efficacy
UV spectra of an aqueous solution with 0.1% propylene glycol of 100 µg/mL of RHS-H alone or mixed with the synthetic UV filter Ethylhexyl Methoxycinnamate, Butyl Methoxydibenzoylmethane, or Octocrylene (5–10 µg/mL dissolved in ethanol) were acquired (UV/Vis spectrometer Specord 200 plus Sotax powered by AnalitykJena, Jena, Germany) in the range 220 and 400 nm. Spectra were recorded against solvent-matched blanks: water with 0.1% propylene glycol for RHS-H; ethanol for individual UV filters; and the corresponding water/propylene glycol–ethanol mixture (same proportions as in the test samples) for RHS-H + filter mixtures. In vitro Sun Protection Factor (SPF) was determined spectrophotometrically between 290 and 320 nm (in 5 nm increments), applying the Mansur equation [25]:
where EE (λ) = Erythemal Effect spectrum; I (λ) = solar intensity spectrum; Abs (λ) = absorbance of the sample; CF = Correction Factor (= 10).
The constants of EE × I were obtained by Sayre et al. 1979 [26] and reported in Table 1.

Table 1.
Normalized values of the product function used in the Mansur Equation (1).
2.3.7. Determination of Minimum Bactericidal Concentration (MBC)
The antibacterial activity of RHS-H was evaluated against S. aureus (ATCC 6538), S. epidermidis (ATCC 03111), Escherichia coli (ATCC 25922), and Pseudomonas aeruginosa (ATCC 9027). Microorganisms were obtained from LGC Standards S.r.L. (Milan, Italy). To determine the in vitro Minimum Bactericidal Concentration (MBC) of the extract, micro-broth dilution assays were performed in line with the Clinical and Laboratory Standards Institute (CLSI) guidelines. In detail, two colonies of each bacterial strain from Mueller–Hinton Agar (MHA, Thermo Fisher Scientific, Milan, Italy) were initially resuspended and grown overnight in Mueller–Hinton Broth (MHB, Thermo Fisher Scientific, Milan, Italy) at 37 °C. Inocula were then prepared by diluting overnight cultures at a concentration of ≈ 106 CFU/mL in fresh MHB. From this suspension, 100 μL was used to inoculate flat-bottom 96-well polystyrene microtiter plates containing two-fold serial dilutions of the extract from 1 mg/mL to 0.25 mg/mL. The minimum bactericidal concentration (MBC) was determined by plating 100 μL of each well or proper serial dilutions on MHA incubated at 37 °C for 24 h. The MBC was identified as the lowest concentration that prevents any microbial growth on an agar plate. Each assay was performed in triplicate on separate days.
2.4. Development and Production of O/W Cosmetic Emulsions
Four cosmetic Oil-in-Water (O/W) emulsions were developed (Table 2). F1, containing synthetic UV filters and preservatives, was used as the control (blank) formulation. F2 was prepared to evaluate RHS-H as a preservative, while F3 combined RHS-H with a reduced amount of synthetic preservative (co-preservative system). To assess the contribution of RHS-H to UV protection, F4 (RHS-H alone) and F3 (RHS-H with UV filters) were compared. For the in vitro SPF evaluation, additional emulsions F5–F8 were prepared: F5 and F6 were identical to F3 but contained 1% and 2% RHS-H, respectively, whereas F7 and F8 were identical to F4 but with 1% and 2% RHS-H.

Table 2.
Qualitative and quantitative of O/W emulsions F1–F4. F1: control with synthetic UV filters and preservatives; F2: RHS-H as preservative; F3: RHS-H as co-preservative with synthetic filters/preservatives; F4: RHS-H as UV-protective agent.
For preparation, the aqueous phase (water + EDTA) was heated to 70 ± 2 °C, and Xanthan Gum pre-dispersed in Glycerin was added. The oily phase was separately heated to the same temperature, and UV filters (Ethylhexyl Methoxycinnamate, Butyl Methoxydibenzoylmethane, and Octocrylene) solubilized in C12-15 Alkyl Benzoate were incorporated just before emulsification. The oil phase was then slowly added to the aqueous phase and emulsified with a turboemulsifier (10 min, 8000 rpm), followed by manual mixing until cooling. At 33 ± 2 °C, preservatives (Phase C) were added to F1, F2, and F3. RHS-H, pre-dispersed in Glycerin and water (Phase D), was incorporated at 25 ± 2 °C in F2, F3, and F4.
2.5. Physico-Chemical Stability Tests
2.5.1. Stability Tests at 25 °C Up to 6 Months
The O/W emulsions were stored at 25 ± 1.0 °C for 6 months. At established times (48 h; 15 and 180 days), the stability in the centrifuge and pH and rheological behavior values were verified.
2.5.2. Heat Shock Cycles
The O/W emulsions were subjected to 3 cycles of heating and cooling. The formulations were stored at 4 °C for 24 h, removed, and directly placed at 50 °C for another 24 h. After 3 cycles, the physicochemical parameters (centrifuge stability, pH, and rheological behavior) of the emulsions were checked.
2.5.3. Centrifugation Stability Test
For each O/W emulsion, 7 g of product were transferred into centrifuge tubes and subjected to accelerated stress conditions using a Labofuge 200 Centrifuge (Thermo Scientific, Waltham, MA, USA). Samples were first spun at 4000 rpm for 30 min. If no evidence of phase separation (e.g., creaming, flocculation, or coalescence) was detected, the same aliquot was further centrifuged at 5300 rpm for 15 min to confirm stability under more stringent conditions [27].
2.5.4. Organoleptic and pH Determination
Macroscopic inspection was carried out to assess visual and olfactory characteristics of the emulsions, including homogeneity, color, appearance, and odor [28]. pH was measured at 25 ± 0.3 °C using a Seven Easy digital pH meter (Mettler Toledo, OH, USA) calibrated with standard buffer solutions (pH 4.04, 7.00, and 9.21). Each value represents the mean of three independent measurements [27].
2.5.5. Zeta Potential
Electrophoretic light scattering (ELS) was employed to determine zeta potential, using a Litesizer 500 Particle Analyzer (Anton Paar GmbH, Graz, Austria) equipped with a 658 nm diode laser, delivering 40 mW, and temperature-controlled at 25 °C. The Smoluchowski approximation was applied to convert electrophoretic mobility into zeta potential values, a method commonly used for particles suspended in aqueous solutions with moderate electrolyte concentrations. Kalliope software version 1.8 was used for data acquisition and analysis. Zeta potential measurements were conducted by diluting the samples at a 1:500 (v/v) ratio, followed by 30 min of stirring. The analysis was performed in a polycarbonate omega cuvette cell with graphite electrodes.
2.6. Rheological Behavior Characterization
Rheological behavior of F1 and F3 emulsions was analyzed with an MCR102 rheometer (Anton Paar, Graz, Austria) equipped with a CP50-1 cone–plate system (diameter 49.980 mm, cone angle 0.989°, truncation 99 µm). Data acquisition and processing were performed using RheoCompass™ software [27]. Both steady-shear and oscillatory tests were conducted. Flow properties were determined by recording viscosity (mPa·s) across shear rates ranging from 0.01 to 1000 s−1 (21 points per decade) within 30 s. Amplitude sweep experiments, performed at a constant frequency of 10 s−1 with strain increasing from 0.01% to 100% (logarithmic mode), were used to define the Linear Viscoelastic Region (LVR). Frequency sweep measurements were then carried out at a constant stress within the LVR, over an angular frequency range of 0.1–100 rad·s−1. All experiments were performed in triplicate at 25.0 ± 1.0 °C.
2.7. Evaluation of Free Radical Scavenging Activity of Formulations
To evaluate the DPPH radical scavenger ability of the cosmetic emulsions (F1-F4), 10 mL of methanol was added to 1 g of each cream, separately. The suspension was vortexed for 30 s, subjected to ultrasound (40 KHz) in a water bath for 20 min, and centrifuged at 5300 rpm for 15 min. 2.5 mL of supernatant was added to 2.5 mL of a methanolic solution of DPPH. Samples were kept in the dark at room temperature for 30 min, and the decrease in absorbance at 517 nm was recorded after 10 and 30 min (spectrophotometer Analytic Jena Specord 200 plus, Thermo Fischer Scientific, Leer, Germany). The results were expressed as Radical Scavenging Activity percentage (RSA%):
where Ac is the absorbance of the control (without the sample) and As is the absorbance of the sample. All tests were performed in triplicate.
2.8. Preservative Efficacy Testing (Challenge Test)
An in vitro challenge test, carried out in accordance with UNI EN ISO 11930:2022 [29], was used to evaluate the preservative efficacy of the formulations.
Emulsions were inoculated with reference bacterial and fungal strains, and microbial counts were monitored over time to verify compliance with acceptance criteria. Each formulation was challenged, respectively, with Staphylococcus aureus (ATCC 6538), Pseudomonas aeruginosa (ATCC 9027), Candida albicans (ATCC 10231), and Aspergillus brasiliensis (ATCC 16404). Microorganisms were obtained from LGC Standards S.r.L. (Milan, Italy).
Formulations were divided into 10 mg aliquots and inoculated with bacterial suspensions at 106/mL or fungal suspensions at 105/mL. Samples were incubated at 20–25 °C. At different time points, 2, 7, 14, and 28 days, one mg aliquots were serially diluted in Muller-Hinton broth or in Yeast nitrogen base broth (YNB, Thermo Fisher Scientific, Milan, Italy) and plated in duplicate on Muller-Hinton Agar (for bacteria) or Sabouraud dextrose agar (SDA, Thermo Fisher Scientific, Milan, Italy) (for fungi). Plates were incubated at 30–35 °C for up to 3 days for bacteria and 20–25 °C for up to 5 days for fungi. Raw microbial counts were converted to log10 values for analysis.
2.9. In Vitro Sun Protection Factor (SPF) Evaluation of the O/W Emulsions
Sun protection factor (SPF) of O/W emulsion systems was estimated through spectrophotometric measurements on film-coated substrates, following the in vitro Diffey–Robson approach [30]. This method provides a more realistic estimation of SPF than solution-based tests. The used method considers the full UV spectrum (290–400 nm), allowing for a rapid assessment of the SPF as well as the study of the product against long-wavelength ultraviolet radiation. Emulsions were applied at 2 mg/cm2 to quartz slides and dried for a few minutes before UV transmittance measurements. A quartz slide was used as a reference. Due to the heterogeneity of the samples during the application of the emulsion on the slides, 20–30 replicas were analyzed. UV transmittance was measured in a UV-vis-NIR Shimadzu 3600 spectrophotometer from 290 to 400 nm at 0.5 nm intervals. The collected transmittance spectra were used to calculate in vitro Sun Protection Factor (SPF) (Equation (2)).
where Eλ = CIE erythemal spectral effectiveness, Bλ = solar spectral irradiance, and Fλ = spectral transmittance of the solid substrate/spectral transmittance of the sample.
In addition, the UVA/UVB ratio and the critical wavelength (Cλ) were calculated from the absorbance spectrum using Equations (3) and (4), respectively.
2.10. Statistical Analyses
Statistical analyses were performed using GraphPad Prism version 10.0 (GraphPad Software, San Diego, CA, USA). One-way analysis of variance (ANOVA) followed by Tukey’s post hoc test was used to assess significant differences among the obtained results. Statistical significance was set at p < 0.05.
3. Results and Discussion
3.1. Production of RHS-H and Chemical Characterization
Hazelnut skins, a by-product of industrial hazelnut processing, were extracted using pressurized liquid extraction (PLE) with aqueous ethanol, a green and efficient technique previously optimized by our group [1]. The process provided high yields (33.2 ± 0.7 g/100 g dry skin) and ensured food-grade compatibility, allowing the production of RHS-H suitable for cosmetic applications. The resulting extract (RHS-H) exhibited a total polyphenol content of 308.4 ± 4.6 mg GAE/g extract and a high concentration of proanthocyanidins (PAs) (169.3 ± 10 mg CE/g extract), comparable to that of one of the most recognized commercial PA-rich extracts, Pycnogenol® (126.1 ± 2.0 mg CE/g extract), derived from the bark of the French maritime pine Pinus pinaster. PAs of RHS-H showed an average degree of polymerization (mDP) of 8.6 ± 0.6. The flavanol profile of RHS-H, characterized by catechin, epicatechin, and galloylated derivatives such as catechin-3-O-gallate, epigallocatechin, gallocatechin, and gallocatechin-3-O-gallate, was consistent with the composition previously identified in detail by our group [1].
3.2. RHS-H Functional Characterization
3.2.1. Scavenging Activity Against DPPH and ABTS Radicals
Identifying natural compounds with antioxidant activity is critical for mitigating damage caused by reactive oxygen species (ROS) to human cellular structures. Among the most common exogenous sources of ROS are air pollution, solar radiation, and cigarette smoke, which promote the accumulation of free radicals in the stratum corneum. These unstable molecules can damage membrane lipids, proteins, and DNA, disrupt collagen fibers organization, and contribute to premature skin aging and the development of skin disorders. The topical application of polyphenol-rich extracts may help counteract these effects by neutralizing free radicals or converting them into less reactive species [31].
RHS-H exhibited strong radical scavenging activity, with an EC50 value of 5.08 ± 1.08 µg/mL against DPPH radicals, outperforming pure catechin (EC50 = 15.82 ± 1.27 µg/mL). In the ABTS assay, RHS-H showed a Trolox Equivalent Antioxidant Capacity (TEAC) of 2.82 ± 0.03 mM Trolox/mg extract, compared to 3.27 ± 0.01 mM Trolox/mg for catechin. The antioxidant potential of roasted hazelnut skin is well-documented and is primarily attributed to the presence of condensed tannins, such as proanthocyanidins, whose flavanol subunits can donate electrons or hydrogen atoms to neutralize radical species and prevent propagation reactions [20]. Based on these properties, some authors have proposed the use of hazelnut skin extracts, obtained using either conventional solvents or innovative systems such as Natural Deep Eutectic Solvents (NADES, a class of bio-based, low-toxicity, and biodegradable green solvents with high solubilizing power), for incorporation into cosmetic formulations [32].
3.2.2. UV Absorbance and In Vitro SPF of Ingredients: RHS-H and Synthetic UV Filters
Beyond the use of exogenous antioxidants, protecting the skin from premature aging and UV-induced damage also requires the use of skincare products containing chemical UV filters that absorb harmful ultraviolet radiation. Polyphenol-rich extracts with antioxidant properties may enhance the performance of synthetic UV filters, allowing for lower active concentrations.
RHS-H displayed effective UV absorption, particularly in the UVC (<280 nm) and UVB (280–320 nm) ranges. The extract showed a peak at 280 nm (Figure 1a–c, dark gray line), characteristic of proanthocyanidins [33] and exhibited strong absorption in the UVC region. When combined with synthetic filters, RHS-H enhanced the overall UV absorption, especially in the UVC and UVB ranges. For Octocrylene, which showed a typical absorption peak between 280 and 320 nm (Figure 1a, light gray line), the addition of RHS-H (dotted line) resulted in a 3.58-fold increase in absorbance. Ethylhexyl Methoxycinnamate combined with RHS-H (Figure 1b, dotted line) exhibited a 1.14-fold increase in absorbance at 310 nm compared to the pure filter. For Butyl Methoxydibenzoylmethane, the addition of RHS-H (Figure 1c, dotted line) broadened the absorption spectrum and enhanced absorption by 9.57-fold at 290 nm and 1.18-fold across the 320–400 nm UVA range.

Figure 1.
UV absorption spectra (220–400 nm) of RHS-H, synthetic UV filters, and their combinations. (a) Octocrylene (light gray line), RHS-H (dark gray line), and their mixture (dotted line); (b) Ethylhexyl Methoxycinnamate (light gray), RHS-H (dark gray), and their mixture (dotted); (c) Butyl Methoxydibenzoylmethane (light gray), RHS-H (dark gray), and their mixture (dotted). RHS-H enhances UV absorbance, particularly in the UVC and UVB regions.
These results indicate that RHS-H can significantly boost the UV-absorbing capacity of synthetic filters. Compared to the study by Ivanović et al. 2020 [34], which found negligible improvement when combining benzophenone-3 with hazelnut skin extracts (10 mg/L, aqueous ethanol 10–50–96%, v/v), our new findings demonstrated markedly superior performance for RHS-H. The synergistic interaction between antioxidant extracts from agri-food by-product and UV filters has also been reported in other studies. Galanakis et al. 2018 [35,36] showed that polyphenols recovered from olive mill wastewater enhanced the UV absorption of both chemical and physical filters, outperforming vitamins C and E, with the booster effect being proportional to polyphenol concentration (0–15 mg/L).
The protective capacity of a formulation against UV radiation is expressed as its Sun Protection Factor (SPF) value. SPF is calculated as the ratio between the minimum UV dose required to produce erythema on protected skin and that on unprotected skin [37]. While in vivo testing is required for regulatory purposes, in vitro spectrophotometric methods are widely used during formulation development. In this study, SPF values were calculated using the Mansur equation, which, despite being limited to estimating protection based on absorbance in the UVB range (290–320 nm) and assuming a linear correlation between absorbance and protective efficacy, provides a rapid and practical screening tool for evaluating substances in solution. RHS-H exhibited an in vitro SPF of 3.63 at 0.1 mg/mL and significantly improved the SPF of the synthetic UV filters. When blended with RHS-H, the SPF values of Octocrylene, Ethylhexyl Methoxycinnamate, and Butyl Methoxydibenzoylmethane increased from 4.90, 3.88, and 3.98 to 9.13, 9.73, and 7.33, respectively (Table 3).

Table 3.
In vitro Sun Protection Factor (SPF) values of RHS-H and its combinations with synthetic UV filters. SPF values were calculated using the Mansur equation. RHS-H enhanced the SPF of all tested filters when used as a booster at 0.1 mg/mL.
These findings are in line with other studies reporting high SPF values for extracts rich in flavan-3-ols and B-type procyanidins. For instance, Liu et al. 2024 [38] reported that Cinnamomum camphora extracts exhibited higher UVB-blocking activity than synthetic filters like benzophenone and homosalate. Similarly, Ferreira et al. 2023 [39] identified polyphenol-rich extracts from onion peel and passion fruit as natural UV filters, with SPF values correlating with gallic acid, resveratrol, and flavonoid content. Extracts from Washingtonia filifera seeds demonstrated SPF values up to 3.35 at 100 µg/mL [40].
The UV-shielding capacity of flavonoids is attributed to their aromatic rings and π-conjugated electronic systems, which enable efficient absorption of UV radiation energy [13].
3.2.3. Antimicrobial Activity
The antimicrobial activity of RHS-H was assessed by determining the Minimum Bactericidal Concentration (MBC) against Gram-positive bacteria (S. aureus and S. epidermidis) and Gram-negative strains (Escherichia coli and Pseudomonas aeruginosa). S. aureus is a major pathogen responsible for superficial and deep skin infections, due to its immune evasion mechanisms and production of multiple virulence factors promoting colonization and inflammation [41]. S. epidermidis, although commonly regarded as a skin commensal, has emerged as an opportunistic pathogen, especially in immunocompromised individuals and in biofilm-associated infections, due to its antimicrobial resistance and immunomodulatory properties [42].
As shown in Figure 2a, RHS-H at 1 mg/mL achieved complete growth inhibition of S. aureus (consistent with MBC criteria), while a concentration of 0.5 mg/mL reduced bacterial viability by over 70%. No significant bactericidal effect was observed at lower concentrations. In the case of S. epidermidis, only a limited reduction (~20%) in viability was recorded at the highest concentration tested, with no complete bactericidal activity. No inhibitory effect was observed against E. coli and P. aeruginosa at concentrations up to 1 mg/mL.

Figure 2.
Bactericidal activity of RHS-H extract. (a) S. aureus and (b) S. epidermidis cultures were incubated with increasing concentrations of RHS-H for 24 h at 37 °C. Colony-forming units (CFU/mL) were quantified to assess viability. CTRL: untreated control; EtOH 3%: solvent control. Data are expressed as mean ± SD of three independent experiments. * p < 0.05, ** p < 0.01 (one-way ANOVA with Tukey’s post hoc test).
The selective antibacterial activity of RHS-H against S. aureus, and to a lesser extent S. epidermidis, is consistent with previous findings on polyphenol-rich hazelnut by-product extracts. Di Michele et al. 2021 [43] reported that ethanol-based extracts from hazelnut shells exhibited higher efficacy against Gram-positive strains, while Gram-negative bacteria remained unaffected. Similarly, Esposito et al. 2020 [21] demonstrated strong antibacterial activity of hazelnut skin extract, incorporated into biodegradable films, specifically against S. aureus. These observations support the hypothesis that proanthocyanidins and flavanols in RHS-H exert membrane-disrupting effects in Gram-positive bacteria. In contrast, the outer lipopolysaccharide layer of Gram-negative species likely limits polyphenol penetration, interaction with the peptidoglycan layer, and overall activity [39,44].
3.3. Design and Development of O/W Cosmetic Emulsions
Based on the promising functional results of RHS-H, a series of Oil-in-Water (O/W) cosmetic emulsions was developed. A base formulation (F1) was designed as a control, while RHS-H was incorporated into formulations F2–F4 to evaluate its performance as a preservative, antioxidant, and UV filter booster.
O/W emulsions were selected as the most suitable delivery system for RHS-H due to the extract composition of molecules with varying polarity. To ensure high skin compatibility and maximize multifunctional efficacy, all formulations were prepared using ingredients approved under European Cosmetic Regulation No. 1223/2009 [6]. The emulsions were stabilized with a non-ionic emulsifier system and featured a lipid phase composed of natural emollients, including Butyrospermum parkii (shea butter), Caprylic/Capric Triglyceride (derived from coconut oil), and Persea gratissima (avocado) oil, all known for their moisturizing and skin-regenerating properties. Dimethicone was added to improve spreadability and minimize the whitening effect commonly observed in O/W formulations. Additional emollient and humectant agents included Ethylhexyl Stearate, Dicaprylyl Ether, and Glycerin [27]. Formulations F1, F3, and F4 contained a preservative blend of Phenoxyethanol and Ethylhexylglycerin. The latter also acts as a skin conditioning agent and synergistically enhances the antimicrobial efficacy of Phenoxyethanol, offering broad-spectrum protection against bacteria, yeasts, and molds. Photoprotection in F1–F3 was achieved by combining the UVB filters Octocrylene and Ethylhexyl Methoxycinnamate with the UVA filter Butyl Methoxydibenzoylmethane, which are commonly used in cosmetic sunscreen formulations [45]. The complete qualitative and quantitative composition of the emulsions is reported in Table 2.
3.4. Stability Studies of O/W Emulsions F1–F4
Following the development of formulations F1–F4, stability tests were performed to evaluate their organoleptic and physicochemical properties, including visual appearance, physical stability, pH, zeta potential, and rheological behavior. Assessments were conducted at predefined intervals during storage at 25 °C and after three thermal shock cycles (alternating between 4 °C and 50 °C).
Organoleptic evaluation is crucial to ensure that sensory properties, such as appearance, color, and odor, remain acceptable over time. This step also verifies that the inclusion of the extract does not compromise consumer appeal. All formulations (F1–F4) retained a homogeneous appearance, with RHS-H visibly well dispersed. As shown in Figure 3a,b, incorporation of RHS-H (0.2% w/w), due to the natural brownie color of the extract, changed the color of the base emulsion from white (F1) to a uniform pinkish hue in F2–F4, without sedimentation or phase separation during the entire observation period.

Figure 3.
Macroscopic appearance of O/W emulsions: (a) control formulation F1 (white); (b) formulations F2–F4 containing RHS-H (pinkish).
Centrifugation testing, which applies mechanical stress to accelerate potential destabilization, confirmed physical stability in all formulations, with no evidence of creaming, precipitation, or phase separation.
pH monitoring is a critical parameter, as deviations may indicate microbial contamination or instability. Furthermore, pH must remain within the skin-compatible range to avoid irritation. Ideal values for semisolid formulations intended for facial use range between 4.0 and 6.0 [46]. Elevated pH may promote microbial growth, whereas highly acidic pH could disrupt the natural skin microbiota. Moreover, many common cosmetic preservatives, particularly organic acids, show higher efficacy in acidic environments due to the predominance of their undissociated active form [47]. Throughout the test period, the pH of F1 remained stable between 5.31 and 5.35 (Figure 4). In contrast, formulations containing RHS-H (F2–F4) showed slightly lower pH values at baseline (4.90–5.27) and further reduction after 180 days (4.75–4.90), although still within the acceptable dermocosmetic range (4.70–5.50). This pH decrease is attributed to the mildly acidic polyphenols in RHS-H, consistent with previous findings. For instance, Pinto et al. 2021 [46] reported a similar pH drop in an O/W emulsion containing Castanea sativa shell extract. Ferreira et al. 2023 [39] also observed that polyphenol-rich extracts from onion and passion fruit peel reduce pH due to the acidic nature of phenolic compounds.

Figure 4.
pH values of emulsions F1–F4 measured at 48 h, 15 days, 180 days, and after thermal shock cycles. Data are presented as mean ± SD (n = 3).
Zeta potential, an indicator of surface charge and emulsion stability, was also measured. Values exceeding ±30 mV are generally considered indicative of good physical stability, as electrostatic repulsion prevents droplet coalescence [48]. After six months and shock stress, all formulations exhibited zeta potential values ranging from –57 to –60 mV (Figure 5), confirming robust colloidal stability. Despite the use of a non-ionic emulsifier, negative surface charges were expected due to the inclusion of xanthan gum, whose glucuronic acid residues contribute to the overall negative charge [49,50,51].

Figure 5.
Zeta potential values of emulsions F1–F4 after 180 days and heat-shock treatment.
3.5. Rheological Behavior Analysis of O/W Emulsions
Rheological properties play a critical role in cosmetic emulsions, influencing not only product stability but also consumer perception. Comprehensive rheological evaluation is essential to assess formulation robustness and monitor changes due to active ingredients and storage conditions [52].
3.5.1. Flow Curve Analysis
Flow curve analysis was performed on F1 (blank) and F3 (containing RHS-H) emulsions to evaluate the impact of the extract on rheological behavior and storage stability. Measurements were taken 24 h after preparation (T0), after six months at 25 °C (T6), and after thermal shock cycles (TS) (Figure 6).

Figure 6.
Flow curves obtained from viscosity (η) as a function of shear rate (γ), for the different formulations (F1 and F3) at different storage conditions. Rheological data are shown as mean ± SD (n = 3).
Both emulsions exhibited shear-thinning (pseudoplastic) behavior, with dynamic viscosity (η) decreasing as shear rate increased. F1 showed viscosity values ranging from 5.06 × 106 to 552.52 mPa·s, while F3 ranged from 5.10 × 106 to 580.88 mPa·s.
This behavior is typical of non-Newtonian fluids such as creams, gels, lotions, and emulsions, and it suggests a semi-flexible molecular structure where aggregates quickly break down and droplets align under high shear, facilitating ease of spreading on the skin [53]. The non-Newtonian behavior observed is largely due to the asymmetric particles within the emulsions, which is a critical attribute for cosmetic products that undergo deformation during application [46,54]. The presence of RHS-H did not affect the flow profile (Figure 6), consistent with previous findings for emulsions containing Castanea sativa bur extracts (Esposito et al., 2021) [27]. The persistence of this shear-thinning profile after six months and thermal stress confirms the rheological stability of both formulations [39]. This is critical for ensuring uniform spreadability and product integrity over time [46,54,55].
3.5.2. Amplitude Sweep Test
Oscillatory amplitude sweep tests were conducted to assess the rigidity and internal structure of the emulsions. The storage modulus (G′) reflects elastic behavior, while the loss modulus (G″) reflects viscous response [56]. The test was carried out at a constant frequency of 10 rad/s, with strain (γ) ranging from 0.01% to 100% at 25 °C.
As shown in Figure 7, both F1 and F3 exhibited a decrease in G′ and an increase in G″ with increasing strain, indicating a transition to more fluid-like behavior under deformation, an important feature for spreadability on the skin [54,57]. The Linear Viscoelastic Region (LVR), where G′ remains constant, extended up to about 0.2% strain for both emulsions, with G′ values exceeding 10 Pa. These data confirm that both formulations possess well-structured internal networks, consistent with their classification as hard-base creams [52]. Additionally, the greater distance between the LVR limit and the G′ = G″ crossover point further reinforces the structural stability of both F1 and F3. The LVR behavior was not altered by the inclusion of RHS-H, indicating that the extract did not compromise the mechanical strength or structural integrity of the emulsion [54].

Figure 7.
Amplitude sweep of F1 and F3: storage modulus (G′) and loss modulus (G″) as a function of strain (γ) at 10 rad/s. Rheological data are shown as mean ± SD (n = 3).
3.5.3. Frequency Sweep Test
The oscillatory frequency sweep tests revealed that both F1 and F3 exhibit predominantly solid-like behavior, as indicated by G′ consistently remaining higher than G″ across the applied frequency domain (Figure 8). The storage and loss moduli did not intersect at low angular frequencies, confirming the solid-like nature and stability of the emulsions by preventing particle or globule sedimentation and phase separation [57,58]. Emulsions are considered non-sticky when no crossover between the elastic and viscous moduli is observed, whereas a crossover indicates sticky behavior [58]. The high storage modulus (G′) values observed in both formulations are essential for ensuring structural stability over time. The linear viscoelastic properties of cosmetic emulsions are closely related to molecular interactions such as cross-linking, entanglement, and aggregation among components, and can be used to assess storage stability at rest. Cosmetic emulsions must maintain predominantly solid-like behavior to preserve their shape and integrity during shelf life. At an angular frequency of 0.1 rad/s, the G′/G″ ratio was 0.42 for F1 and 0.57 for F3, indicating that the elastic component dominates and reinforces their gel-like character. The storage modulus at low frequencies (ω ≤ 0.1 rad/s), referred to as G′0, provides further insight into the system’s stability at rest. Ideally, the G′ curve should show a negligible slope in this region. Experimental evidence suggests that for many dispersions and gels, G′0 ≥ 10 Pa (with G′ > G″) confirms a gel-like character and ensures stable dispersion. Conversely, G′0 ≤ 1 Pa indicates insufficient stability, while intermediate values require complementary tests such as yield stress and flow point analysis. In this study, the measured G′0 values were 995.23 Pa for F1 and 1083.2 Pa for F3, confirming excellent stability for both formulations, as their G′0 values largely exceeded the 10 Pa threshold. Additionally, the incorporation of RHS-H did not alter the intrinsic viscoelastic properties, as F3 maintained its elastic nature across the entire frequency range [59].

Figure 8.
Frequency sweep of F1 (blue lines) and F3 (red lines): storage modulus (G′) and loss modulus (G″) plotted as a function of angular frequency (ω). Rheological data are shown as mean ± SD (n = 3).
3.6. Evaluation of Antioxidant Activity of Emulsions F1–F4
Topical application of antioxidant-rich products is an effective strategy to counteract the depletion of endogenous antioxidants caused by environmental stressors such as pollution and UV exposure [60]. UV irradiation induces free radicals that impair skin barrier function, making antioxidants an essential component of sunscreen formulations. In addition to their direct protective role, antioxidants can enhance sunscreen efficacy by stabilizing UV filters, improving their photoprotection, and preventing oxidative degradation [35,61]. For example, Wu et al. 2011 [62] demonstrated that the combination of antioxidants, including ascorbyl phosphate, tocopherol acetate, Echinacea pallida extract, chamomile extract, and caffeine, with broad-spectrum sunscreens (benzophenone, butyl methoxydibenzoylmethane, avobenzone, and methoxycinnamate) significantly increased protection by reducing pigment formation, cytokeratin induction, UV-induced hyperproliferation, and the expression of photoaging markers such as matrix metalloproteinases (e.g., MMP-9).
In this study, the blank emulsion F1 exhibited radical scavenging activity (RSA) of 31.5% and 52.0% after 10 and 30 min of incubation with DPPH, respectively. This effect is likely due to ingredients with intrinsic antioxidant properties, such as Persea gratissima (avocado) oil and Butylated Hydroxytoluene (BHT). Avocado oil is naturally rich in tocopherols, carotenoids, and phytosterols, all of which can scavenge free radicals and protect skin lipids from peroxidation [63]. BHT, a synthetic phenolic antioxidant, is widely used in cosmetic and pharmaceutical products to stabilize lipids and prevent oxidative degradation [64]. The incorporation of RHS-H into emulsions F2, F3, and F4 significantly enhanced their radical scavenging capacity compared to F1. After 30 min of incubation, RSA increased from 52.0% in the blank formulation to 80.5%, 81.7%, and 84.5% in the RHS-H-enriched emulsions, respectively (Figure 9). These results confirm that RHS-H contributes substantially to the antioxidant potential of emulsions, complementing the activity of other formulation components and improving overall efficacy.

Figure 9.
Radical Scavenging Activity (RSA, %) of formulations F1–F4 after 10 and 30 min of incubation with DPPH radical. Data are expressed as mean ± SD (n = 3). Data are expressed as mean ± SD of three independent experiments. * p < 0.05, *** p < 0.001, **** p < 0.0001 (one-way ANOVA with Tukey’s post hoc test).
3.7. Assessment of RHS-H Preservative Performance in Developed O/W Emulsions: Challenge Test
Microbiological stability is a critical parameter to ensure the quality, safety, and shelf-life of cosmetic products. Contamination can alter the organoleptic and physicochemical characteristics of formulations, leading to degradation and potential adverse effects for consumers. To assess the preservative potential of RHS-H, emulsions F1 (synthetic preservative only, Phenoxyethanol + Ethylhexylglycerin, 1% w/w), F2 (RHS-H only, 0.2% w/w), and F3 (synthetic preservative 0.5% w/w + RHS-H 0.2% w/w) were subjected to a Challenge Test. The concentration of synthetic preservative in F3 was deliberately reduced below the manufacturer’s recommended range (0.6–1.0% w/w) to evaluate the potential co-preservative effect of RHS-H. The results were interpreted according to UNI EN ISO 11930:2022, which considers a formulation well preserved if it achieves: (i) a ≥3 log reduction in bacterial counts within 7 days (criteria A) or within 14 days (criteria B), (ii) a ≥1 log reduction in Candida albicans within 7 or 14 days, with no regrowth observed up to day 28, and (iii) no proliferation of Aspergillus brasiliensis, with a ≥1 log reduction required by day 28 (criteria A).
All formulations (F1–F3) satisfied criteria A for bacterial effectiveness. A complete inhibition of Staphylococcus aureus and Pseudomonas aeruginosa growth was observed in F1, F2, and F3 after 2 and 7 days, respectively (Figure 10 and Figure 11). Remarkably, RHS-H alone (F2) performed comparably to the synthetic preservative system (F1), confirming its intrinsic antibacterial activity. Notably, while raw RHS-H shows no effect against Gram-negative bacteria, its incorporation into the emulsion matrix enabled full protection against P. aeruginosa. This enhancement may result from formulation excipients: Nostro et al. 2002 [65] demonstrated that EDTA disrupts Gram-negative outer membranes by chelating Ca2+ and Mg2+ ions, thereby facilitating penetration of antimicrobial agents such as essential oils. A similar mechanism could explain the improved efficacy of RHS-H in emulsions.

Figure 10.
Challenge test with S. aureus of the formulations. (A) Representative images of plates following inoculation with S. aureus in F1 (synthetic preservative, 1% w/w), F2 (RHS-H, 0.2% w/w), and F3 (synthetic preservative, 0.5% w/w + RHS-H, 0.2% w/w). (B) Quantitative reduction of S. aureus at different time points (2, 7, 14, and 28 days) expressed as log10 CFU/mL. The table summarizes bacterial recovery, where “NR” indicates “No Recovery”. Each data point represents the mean ± standard deviation from triplicate experiments.

Figure 11.
Challenge test with P. aeruginosa of the formulations. (A) Representative images of plates following inoculation with P. aeruginosa. (B) Quantitative reduction expressed as log10 CFU/mL for F1–F3 formulations at different time points (2, 7, 14, and 28 days). The table summarizes results, with “NR” = “No Recovery”. Each data point represents the mean ± standard deviation from triplicate experiments.
Regarding antifungal activity, all three formulations completely inhibited A. brasiliensis growth over 28 days (Figure 12). F3 achieved the most rapid response, reaching >1 log reduction by day 2, suggesting synergism between RHS-H and the reduced preservative dose. F2 alone displayed antifungal performance comparable to F1.
Figure 12.
Challenge test with A. brasiliensis of the formulations. (A) Representative images of plates following inoculation with A. brasiliensis. (B) Quantitative reduction expressed as log10 CFU/mL for F1–F3 formulations at different time points (2, 7, 14, and 28 days). The table summarizes results, with “NR” indicates “No Recovery” of fungal growth, while “R” indicates “Recovery”. Each data point represents the mean ± standard deviation from triplicate experiments.
In contrast, the activity against C. albicans was more limited. RHS-H alone (F2) resulted in <1 log reduction after 14 days, insufficient to meet criterion A. However, F3 (RHS-H + half-dose preservative) achieved complete inhibition by day 14, satisfying criterion B (Figure 13). These results indicate that RHS-H enhances antifungal efficacy when combined with lower amounts of synthetic preservatives, acting as an effective co-preservative.

Figure 13.
Challenge test with C. albicans of the formulations. (A) Representative images of plates following inoculation with C. albicans. (B) Quantitative reduction expressed as log10 CFU/mL for F1–F3 formulations at different time points (2, 7, 14, and 28 days). The table summarizes results, with “NR” indicates “No Recovery” of fungal growth, while “R” indicates “Recovery”. Each data point represents the mean ± standard deviation from triplicate experiments.
Taking together, these findings highlight that RHS-H provides strong preservative activity against S. aureus, P. aeruginosa, and A. brasiliensis, and acts as a co-preservative against C. albicans, enabling a reduction in synthetic preservative levels below the standard threshold required for efficacy. Importantly, product protection from Candida contamination could be further reinforced by adopting packaging strategies such as pump dispensers, pressurized containers, or single-dose units, which minimize exposure to air and microorganisms.
Our results are particularly promising given that other studies have reported preservative effects of plant extracts only at much higher concentrations (5–20% w/w). For example, Boukhira et al. 2017 [66] showed that Silene vulgaris extract (10–20% w/w) reduced microbial growth in creams, while Carvalho et al. 2024 [14] demonstrated preservative properties of sugarcane straw polyphenols in 5% emulsions. Similarly, Morus nigra leaf extracts (10–20% w/w) inhibited microbial growth within 7 days [67]. However, such high concentrations often compromise product aesthetics, leading to undesirable coloration (green to dark brown) and changes in viscosity or spreadability. By contrast, RHS-H proved effective at only 0.2% w/w, representing a significant advantage for the development of multifunctional phytocosmetics.
3.8. In Vitro Evaluation of SPF of O/W Cosmetic Formulations
Sun protection remains a major concern in dermatology and cosmetics due to the well-documented harmful effects of solar UV radiation. While UVC is absorbed by the ozone layer, both UVB and UVA contribute to erythema, photoaging, and skin cancer [68]. In this study, the UV protection efficacy of the developed formulations was assessed using the Diffey and Robson in vitro method, which provides a realistic approximation of SPF values by measuring product transmittance on a solid substrate.
No significant differences were observed in UV transmittance between F1 and F3 (Figure 14), both exhibiting high absorbance across the UVB and UVA ranges. The inclusion of RHS-H at 0.2% w/w produced a modest SPF increase, with F3 showing a 9.4% improvement over F1. More substantial enhancement was achieved at higher extract concentrations (1–2% w/w in F5 and F6), which resulted in SPF increases of 22.4% and 44.8%, respectively. However, these concentrations negatively affected the cream organoleptic properties, particularly their color (Figure 15).

Figure 14.
UV transmittance spectra of formulations F1, F3–F8 in the 290–400 nm range. Measurements were performed by Diffey and Robson in vitro method to assess SPF and broad-spectrum protection.

Figure 15.
Macroscopic appearance of formulations containing 1% (F5) and 2% (F6) w/w RHS-H, showing the impact of extract concentration on the color of the cream.
Although RHS-H displayed UVB absorbance in solutions, within emulsions it acted as a broad-spectrum protector, extending coverage to both UVA and UVB regions (see F4 in Figure 14). This was confirmed by the critical wavelength values (>370 nm) and a UVA/UVB ratio close to 0.78 (Table 4).

Table 4.
In vitro photoprotection parameters of O/W emulsions containing RHS-H: Sun Protection Factor (SPF), UVA/UVB ratio, and critical wavelength (Cλ). Values are reported as mean ± standard deviation (n = 3).
The formulation F4, containing 0.2% RHS-H. would comply with the minimum requirement set by the U.S. FDA, which classifies a product as a sunscreen when the SPF is ≥ 2. In contrast, under the European regulation, sunscreens are defined as products with SPF values between 6 and 50 [69]. According to this higher standard, RHS-H alone did not provide sufficient photoprotective efficacy, as even at concentrations up to 2% w/w (F7 and F8), the SPF values remained below the threshold, reaching only 5.2 and 5.6, respectively.
These findings are consistent with previous studies on polyphenol-rich extracts. Hübner et al. 2020 [70] reported limited SPF for grape pomace extract used alone, but a significant SPF boost when combined with conventional UV filters. Similarly, Cefali et al. 2019 [54] observed that although flavonoid-rich extracts exhibited UVA and UVB absorbance in solutions, their incorporation into emulsions did not significantly enhance SPF [54]. This highlights a common limitation of natural phenolic compounds: despite their intrinsic UV-absorbing capacity, their SPF contribution in formulations is limited unless applied at high concentrations, which can compromise product aesthetics.
Nonetheless, natural extracts such as RHS-H remain of high interest because, beyond direct UV absorption, they may stabilize synthetic UV filters and provide additional cosmetic benefits, including antioxidant, antimicrobial, and anti-inflammatory activities [70,71].
4. Conclusions
Roasted hazelnut skins, traditionally regarded as an agro-industrial by-product, can be successfully upcycled into RHS-H, a natural multifunctional cosmetic ingredient. At low concentrations, RHS-H was successfully incorporated into O/W emulsions, enhancing antioxidant defense, photoprotection, and preservative performance. This sustainable extract offers a valuable opportunity to replace or complement synthetic additives, meeting industry needs for effective, green raw materials while aligning with consumer demand for safe, plant-based cosmetics.
Author Contributions
Conceptualization, T.E. and T.M.; methodology, T.E., F.S., and T.M.; investigation, T.M., T.E., D.E., M.P., A.L.P., C.F., and O.G.; data curation, T.M., T.E., G.A., and F.S.; writing—original draft preparation, T.E., D.E., A.L.P., O.G. and T.M.; writing—review and editing, T.E., D.E., A.L.P., O.G., F.S., and T.M.; supervision, R.P.A.; funding acquisition, T.M., L.R., and O.G. All authors have read and agreed to the published version of the manuscript.
Funding
T.E., F.S., and T.M. are grateful for the financial support by the European Union—Next-GenerationEU—National Recovery and Resilience Plan (NRRP)—MISSION 4 COMPONENT 2, INVESTIMENT N. 1.1, CALL PRIN 2022 D.D. 104 02-02-2022—Sustainable technologies to produce MIcroalGaL bIOmass and agRo-industrial wastes extracts and their novel Application as active coating materials for pREserving fresh cut fruits and vegetables quality (MIGLIORARE) (Project code P2022WT79B) CUP N. D53D2302209 0001. A.P. and L.R. are grateful for the financial support by the European Union—NextGenerationEU, through the National Recovery and Resilience Plan of Italian Ministry of University and Research, Mission 4 Component 2 Investment 1.4—Call for tender No. 3138 of 16 December 2021, rectified by Decree n.3175 of 18 December 2021, Award Number: Project code CN_00000033, Concession Decree No. 1034 of 17 June 2022 adopted by the Italian Ministry of University and Research, CUP: D43C22001260001, Project title “National Biodiversity Future Center—NBFC”. O.G. acknowledges the grant RYC-2021-031328-I funded by MICIU/AEI/ 10.13039/501100011033 and by the European Union NextGenerationEU/PRTR. Financial support from the Basque Country Government in the frame of Consolidated groups (IT-1690-22) is also acknowledged. This manuscript reflects only the authors’ views and opinions, neither the European Union nor the European Commission can be considered responsible for them.
Institutional Review Board Statement
Not applicable.
Informed Consent Statement
Not applicable.
Data Availability Statement
Data are contained within the article.
Conflicts of Interest
Carlo Ferniani is affiliated with Aphros Cosmetics Srl. However, he has not received any research grants, honoraria, consultancy fees, or holds any financial interests that could be perceived as influencing the outcomes of this work. All other authors declare no conflicts of interest.
Abbreviations
The following abbreviations are used in this manuscript:
| RHS | Roasted Hazelnut Skins |
| RHS-H | Roasted Hazelnut Skin Hydroalcoholic extract |
| GAE | Gallic Acid Equivalents |
| CE | Catechin Equivalents |
| DPPH | 1,1-Diphenyl-2-picrylhydrazyl radical |
| TEAC | Trolox Equivalent Antioxidant Capacity |
| UV | Ultraviolet |
| O/W | Oil in Water |
| SPF | Sun Protection Factor |
| ROS | Reactive Oxygen Species |
| DNA | Deoxyribonucleic acid |
| PBS | Phosphate-Buffered Saline |
| ABTS | 2,2′-Azino-bis(3-ethylbenzothiazoline-6-sulfonic acid) |
| EDTA | Ethylenediaminetetraacetic acid |
| PLE | Pressurized Liquid Extraction |
| HPLC-UV-HRMS | High Performance Liquid Chromatography-Ultraviolet-High Resolution Mass Spectrometry |
| HPLC-UV | High Performance Liquid Chromatography-Ultraviolet |
| EC50 | Effective scavenger Concentration50 |
| TE | Trolox Equivalents |
| MBC | Minimum Bactericidal Concentration |
| MHB | Mueller–Hinton Broth |
| MHA | Mueller–Hinton Agar |
| ELS | Electrophoretic Light Scattering |
| LVR | Linear Viscoelastic Region |
| RSA | Radical Scavenging Activity |
| PAs | Proanthocyanidins |
| mDP | average Degree of Polymerization |
| CTRL | untreated control |
| EtOH | Ethanol |
| BHT | Butylated Hydroxytoluene |
| NR | No Recovery |
| R | Recovery |
| FDA | Food and Drug Administration |
References
- Piccinelli, A.L.; Pagano, I.; Esposito, T.; Mencherini, T.; Porta, A.; Petrone, A.M.; Gazzerro, P.; Picerno, P.; Sansone, F.; Rastrelli, L.; et al. HRMS Profile of a Hazelnut Skin Proanthocyanidin-Rich Fraction with Antioxidant and Anti-Candida Albicans Activities. J. Agric. Food Chem. 2016, 64, 585–595. [Google Scholar] [CrossRef]
- Spagnuolo, L.; Della Posta, S.; Fanali, C.; Dugo, L.; De Gara, L.; Gugliucci, A. Antioxidant and Antiglycation Effects of Polyphenol Compounds Extracted from Hazelnut Skin on Advanced Glycation End-Products (AGEs) Formation. Antioxidants 2021, 10, 424. [Google Scholar] [CrossRef]
- Zhao, J.; Wang, X.; Lin, H.; Lin, Z. Hazelnut and Its By-Products: A Comprehensive Review of Nutrition, Phytochemical Profile, Extraction, Bioactivities and Applications. Food Chem. 2023, 413, 135576. [Google Scholar] [CrossRef] [PubMed]
- Frazzini, S.; Zuorro, A.; Panseri, S.; Pavlovic, R.; Sgoifo Rossi, C.A.; Rossi, L. Repurposing Hazelnut Waste Products for a Sustainable Economy: A Metabolomic Analysis of Cuticles and Shells to Highlight Their Antioxidant Potential and Inhibitory Activity against Verocytotoxic Escherichia coli. Sustainability 2023, 15, 3268. [Google Scholar] [CrossRef]
- Nie, F.; Liu, L.; Cui, J.; Zhao, Y.; Zhang, D.; Zhou, D.; Wu, J.; Li, B.; Wang, T.; Li, M.; et al. Oligomeric Proanthocyanidins: An Updated Review of Their Natural Sources, Synthesis, and Potentials. Antioxidants 2023, 12, 1004. [Google Scholar] [CrossRef] [PubMed]
- EC 1223/2009; Regulation (EC) No 1223/2009 of the European Parliament and of the Council on Cosmetic Products. European Union: Brussels, Belgium, 2009.
- Rathee, P.; Sehrawat, R.; Rathee, P.; Khatkar, A.; Akkol, E.K.; Khatkar, S.; Redhu, N.; Türkcanoğlu, G.; Sobarzo-Sánchez, E. Polyphenols: Natural Preservatives with Promising Applications in Food, Cosmetics and Pharma Industries; Problems and Toxicity Associated with Synthetic Preservatives; Impact of Misleading Advertisements; Recent Trends in Preservation and Legislation. Materials 2023, 16, 4793. [Google Scholar] [CrossRef]
- Jesus, A.; Sousa, E.; Cruz, M.T.; Cidade, H.; Lobo, J.M.S.; Almeida, I.F. UV Filters: Challenges and Prospects. Pharmaceuticals 2022, 15, 263. [Google Scholar] [CrossRef]
- Pourzand, C.; Albieri-Borges, A.; Raczek, N.N. Shedding a New Light on Skin Aging, Iron-and Redox-Homeostasis and Emerging Natural Antioxidants. Antioxidants 2022, 11, 471. [Google Scholar] [CrossRef]
- Masaki, H. Role of Antioxidants in the Skin: Anti-Aging Effects. J. Dermatol. Sci. 2010, 58, 85–90. [Google Scholar] [CrossRef]
- Petruk, G.; Del Giudice, R.; Rigano, M.M.; Monti, D.M. Antioxidants from Plants Protect against Skin Photoaging. Oxidative Med. Cell. Longev. 2018, 2018, 1454936. [Google Scholar] [CrossRef]
- Ngoc, L.T.N.; van Tran, V.; Moon, J.Y.; Chae, M.; Park, D.; Lee, Y.C. Recent Trends of Sunscreen Cosmetic: An Update Review. Cosmetics 2019, 6, 64. [Google Scholar] [CrossRef]
- Saewan, N.; Jimtaisong, A. Natural Products as Photoprotection. J. Cosmet. Dermatol. 2015, 14, 47–63. [Google Scholar] [CrossRef] [PubMed]
- Carvalho, M.J.; Pedrosa, S.S.; Pintado, M.; Oliveira, A.L.S.; Madureira, A.R. New Natural and Sustainable Cosmetic Preservative Based on Sugarcane Straw Extract. Molecules 2024, 29, 3928. [Google Scholar] [CrossRef]
- Silvério, L.A.L.; Coco, J.C.; de Macedo, L.M.; dos Santos, É.M.; Sueiro, A.C.; Ataide, J.A.; Tavares, G.D.; Paiva-Santos, A.C.; Mazzola, P.G. Natural Product-Based Excipients for Topical Green Formulations. Sustain. Chem. Pharm. 2023, 33, 1426. [Google Scholar] [CrossRef]
- Zagoskina, N.V.; Zubova, M.Y.; Nechaeva, T.L.; Kazantseva, V.V.; Goncharuk, E.A.; Katanskaya, V.M.; Baranova, E.N.; Aksenova, M.A. Polyphenols in Plants: Structure, Biosynthesis, Abiotic Stress Regulation, and Practical Applications (Review). Int. J. Mol. Sci. 2023, 24, 13874. [Google Scholar] [CrossRef]
- Gomez-Molina, M.; Albaladejo-Marico, L.; Yepes-Molina, L.; Nicolas-Espinosa, J.; Navarro-León, E.; Garcia-Ibañez, P.; Carvajal, M. Exploring Phenolic Compounds in Crop By-Products for Cosmetic Efficacy. Int. J. Mol. Sci. 2024, 25, 5884. [Google Scholar] [CrossRef] [PubMed]
- Matos, M.S.; Romero-Díez, R.; Álvarez, A.; Bronze, M.R.; Rodríguez-Rojo, S.; Mato, R.B.; Cocero, M.J.; Matias, A.A. Polyphenol-Rich Extracts Obtained from Winemakingwaste Streams as Natural Ingredients with Cosmeceutical Potential. Antioxidants 2019, 8, 355. [Google Scholar] [CrossRef]
- Farhan, M. The Promising Role of Polyphenols in Skin Disorders. Molecules 2024, 29, 865. [Google Scholar] [CrossRef]
- Gǎlbǎu, C.Ş.; Irimie, M.; Neculau, A.E.; Dima, L.; Pogačnik da Silva, L.; Vârciu, M.; Badea, M. The Potential of Plant Extracts Used in Cosmetic Product Applications—Antioxidants Delivery and Mechanism of Actions. Antioxidants 2024, 13, 1425. [Google Scholar] [CrossRef]
- Esposito, T.; Silva, N.H.C.S.; Almeida, A.; Silvestre, A.J.D.; Piccinelli, A.; Aquino, R.P.; Sansone, F.; Mencherini, T.; Vilela, C.; Freire, C.S.R. Valorisation of Chestnut Spiny Burs and Roasted Hazelnut Skins Extracts as Bioactive Additives for Packaging Films. Ind. Crops Prod. 2020, 151, 112491. [Google Scholar] [CrossRef]
- Butler, L.G.; Price, M.L.; Brotherton, J.E. Vanillin Assay for Proanthocyanidins (Condensed Tannins): Modification of the Solvent for Estimation of the Degree of Polymerization. J. Agric. Food Chem. 1982, 30, 1087–1089. [Google Scholar] [CrossRef]
- Gu, L.; Kelm, M.; Hammerstone, J.F.; Beecher, G.; Cunningham, D.; Vannozzi, S.; Prior, R.L. Fractionation of Polymeric Procyanidins from Lowbush Blueberry and Quantification of Procyanidins in Selected Foods with an Optimized Normal-Phase HPLC-MS Fluorescent Detection Method. J. Agric. Food Chem. 2002, 50, 4852–4860. [Google Scholar] [CrossRef] [PubMed]
- Esposito, T.; Celano, R.; Pane, C.; Piccinelli, A.L.; Sansone, F.; Picerno, P.; Zaccardelli, M.; Aquino, R.P.; Mencherini, T. Chestnut (Castanea sativa Miller.) Burs Extracts and Functional Compounds: Uhplc-Uv-Hrms Profiling, Antioxidant Activity, and Inhibitory Effects on Phytopathogenic Fungi. Molecules 2019, 24, 302. [Google Scholar] [CrossRef] [PubMed]
- Reis Mansur, M.C.P.P.; Leitão, S.G.; Cerqueira-Coutinho, C.; Vermelho, A.B.; Silva, R.S.; Presgrave, O.A.F.; Leitão, Á.A.C.; Leitão, G.G.; Ricci-Júnior, E.; Santos, E.P. In Vitro and in Vivo Evaluation of Efficacy and Safety of Photoprotective Formulations Containing Antioxidant Extracts. Rev. Bras. Farmacogn. 2016, 26, 251–258. [Google Scholar] [CrossRef]
- Sayre, R.M.; Agin, P.P.; Levee, G.J.; Maruiwe, E. A comparison of in vivo and in vitro testing of sunscreening formulas. Photochem. Photobiol. 1979, 29, 559–566. [Google Scholar] [CrossRef]
- Esposito, T.; Mencherini, T.; Sansone, F.; Auriemma, G.; Gazzerro, P.; Puca, R.V.; Iandoli, R.; Aquino, R.P. Development, Characterization, and Clinical Investigation of a New Topical Emulsion System Containing a Castanea Sativa Spiny Burs Active Extract. Pharmaceutics 2021, 13, 1634. [Google Scholar] [CrossRef]
- Serra, M.; Botelho, C.; Almeida, H.; Casas, A.; Teixeira, J.A.; Barros, A.N. Stable and Functional Cosmetic Creams Enriched with Grape Stem Extract: A Sustainable Skincare Strategy. Antioxidants 2025, 14, 784. [Google Scholar] [CrossRef]
- Caruso, C.; Porta, A.; Tosco, A.; Eletto, D.; Pacente, L.; Bartollino, S.; Costagliola, C. A Novel Vitamin E TPGS-Based Formulation Enhances Chlorhexidine Bioavailability in Corneal Layers. Pharmaceutics 2020, 12, 642. [Google Scholar] [CrossRef]
- Diffey, B.L.; Robson, J. A New Substrate to Measure Sunscreen Protection Factors throughout the Ultraviolet Spectrum. J. Soc. Cosmet. Chem. 1989, 40, 127–133. [Google Scholar]
- Michalak, M. Plant-Derived Antioxidants: Significance in Skin Health and the Ageing Process. Int. J. Mol. Sci. 2022, 23, 585. [Google Scholar] [CrossRef]
- Bencresciuto, G.F.; Carnevale, M.; Paris, E.; Gallucci, F.; Santangelo, E.; Migliori, C.A. A Sustainable Alternative for Cosmetic Applications: NADES Extraction of Bioactive Compounds from Hazelnut By-Products. Sustainability 2025, 17, 1516. [Google Scholar] [CrossRef]
- Ku, C.S.; Mun, S.P. Characterization of Proanthocyanidin in Hot Water Extract Isolated from Pinus Radiata Bark. Wood Sci. Technol. 2007, 41, 235–247. [Google Scholar] [CrossRef]
- Ivanović, S.; Avramović, N.; Dojčinović, B.; Trifunović, S.; Novaković, M.; Tešević, V.; Mandić, B. Chemical Composition, Total Phenols and Flavonoids Contents and Antioxidant Activity as Nutritive Potential of Roasted Hazelnut Skins (Corylus avellana L.). Foods 2020, 9, 430. [Google Scholar] [CrossRef]
- Galanakis, C.M.; Tsatalas, P.; Galanakis, I.M. Phenols from Olive Mill Wastewater and Other Natural Antioxidants as UV Filters in Sunscreens. Environ. Technol. Innov. 2018, 9, 160–168. [Google Scholar] [CrossRef]
- Galanakis, C.M.; Tsatalas, P.; Galanakis, I.M. Implementation of Phenols Recovered from Olive Mill Wastewater as UV Booster in Cosmetics. Ind. Crops Prod. 2018, 111, 30–37. [Google Scholar] [CrossRef]
- Gaweł-Bęben, K.; Kukula-Koch, W.; Hoian, U.; Czop, M.; Strzępek-Gomółka, M.; Antosiewicz, B. Characterization of Cistus × incanus L. and Cistus ladanifer L. Extracts as Potential Multifunctional Antioxidant Ingredients for Skin Protecting Cosmetics. Antioxidants 2020, 9, 202. [Google Scholar] [CrossRef] [PubMed]
- Liu, Z.; Liao, H.; Dai, Y.; Qi, Y.; Zou, Z. Characterization and Anti-Ultraviolet Radiation Activity of Proanthocyanidin-Rich Extracts from Cinnamomum camphora by Ultrasonic-Assisted Method. Molecules 2024, 29, 796. [Google Scholar] [CrossRef]
- Ferreira, S.M.; Gomes, S.M.; Santos, L. A Novel Approach in Skin Care: By-Product Extracts as Natural UV Filters and an Alternative to Synthetic Ones. Molecules 2023, 28, 2037. [Google Scholar] [CrossRef]
- Era, B.; Floris, S.; Sogos, V.; Porcedda, C.; Piras, A.; Medda, R.; Fais, A.; Pintus, F. Anti-Aging Potential of Extracts from Washingtonia filifera Seeds. Plants 2021, 10, 151. [Google Scholar] [CrossRef]
- Krishna, S.; Miller, L.S. Host-Pathogen Interactions between the Skin and Staphylococcus Aureus. Curr. Opin. Microbiol. 2012, 15, 28–35. [Google Scholar] [CrossRef]
- Severn, M.M.; Horswill, A.R. Staphylococcus Epidermidis and Its Dual Lifestyle in Skin Health and Infection. Nat. Rev. Microbiol. 2023, 21, 97–111. [Google Scholar] [CrossRef]
- Di Michele, A.; Pagano, C.; Allegrini, A.; Blasi, F.; Cossignani, L.; Di Raimo, E.; Faieta, M.; Oliva, E.; Pittia, P.; Primavilla, S.; et al. Hazelnut Shells as Source of Active Ingredients: Extracts Preparation and Characterization. Molecules 2021, 26, 6607. [Google Scholar] [CrossRef]
- Harfoush, A.; Swaidan, A.; Khazaal, S.; Salem Sokhn, E.; Grimi, N.; Debs, E.; Louka, N.; El Darra, N. From Spent Black and Green Tea to Potential Health Boosters: Optimization of Polyphenol Extraction and Assessment of Their Antioxidant and Antibacterial Activities. Antioxidants 2024, 13, 1588. [Google Scholar] [CrossRef] [PubMed]
- Nitulescu, G.; Lupuliasa, D.; Adam-Dima, I.; Nitulescu, G.M. Ultraviolet Filters for Cosmetic Applications. Cosmetics 2023, 10, 101. [Google Scholar] [CrossRef]
- Pinto, D.; Lameirão, F.; Delerue-Matos, C.; Rodrigues, F.; Costa, P. Characterization and Stability of a Formulation Containing Antioxidants-Enriched Castanea sativa Shells Extract. Cosmetics 2021, 8, 49. [Google Scholar] [CrossRef]
- Tang, Z.; Du, Q. Mechanism of Action of Preservatives in Cosmetics. J. Dermatol. Sci. Cosmet. Technol. 2024, 1, 100054. [Google Scholar] [CrossRef]
- Singh, S.; Lohani, A.; Mishra, A.K.; Verma, A. Formulation and Evaluation of Carrot Seed Oil-Based Cosmetic Emulsions. J. Cosmet. Laser Ther. 2019, 21, 99–107. [Google Scholar] [CrossRef]
- Mirhosseini, H.; Tan, C.P.; Hamid, N.S.A.; Yusof, S. Effect of Arabic Gum, Xanthan Gum and Orange Oil Contents on ζ-Potential, Conductivity, Stability, Size Index and PH of Orange Beverage Emulsion. Colloids Surf. A Physicochem. Eng. Asp. 2008, 315, 47–56. [Google Scholar] [CrossRef]
- Saharudin, S.H.; Ahmad, Z. Role of Xanthan Gum on Physicochemical and Rheological Properties of Rice Bran Oil Emulsion. Int. Food Res. J. 2016, 23, 1361. [Google Scholar]
- de Oliveira Paulo, L.A.; Fernandes, R.N.; Simiqueli, A.A.; Rocha, F.; dos Santos Dias, M.M.; Minim, V.P.R.; Minim, L.A.; Vidigal, M.C.T.R. Baru Oil (Dipteryx alata Vog.) Applied in the Formation of O/W Nanoemulsions: A Study of Physical-Chemical, Rheological and Interfacial Properties. Food Res. Int. 2023, 170, 112961. [Google Scholar] [CrossRef]
- Danila, A.; Ibanescu, S.A.; Zaharia, C.; Muresan, E.I.; Popescu, A.; Danu, M.; Rotaru, V. Eco-Friendly O/W Emulsions with Potential Application in Skincare Products. Colloids Surf. A Physicochem. Eng. Asp. 2021, 612, 125969. [Google Scholar] [CrossRef]
- Huynh, A.; Garcia, A.G.; Young, L.K.; Szoboszlai, M.; Liberatore, M.W.; Baki, G. Measurements Meet Perceptions: Rheology–Texture–Sensory Relations When Using Green, Bio-Derived Emollients in Cosmetic Emulsions. Int. J. Cosmet. Sci. 2021, 43, 11–19. [Google Scholar] [CrossRef] [PubMed]
- Cefali, L.C.; Ataide, J.A.; Fernandes, A.R.; Sousa, I.M.D.O.; Gonçalves, F.C.D.S.; Eberlin, S.; Dávila, J.L.; Jozala, A.F.; Chaud, M.V.; Sanchez-Lopez, E.; et al. Flavonoid-Enriched Plant-Extract-Loaded Emulsion: A Novel Phytocosmetic Sunscreen Formulation with Antioxidant Properties. Antioxidants 2019, 8, 443. [Google Scholar] [CrossRef]
- López-Hortas, L.; Falqué, E.; Domínguez, H.; Torres, M.D. Microwave Hydrodiffusion and Gravity versus Conventional Distillation for Acacia Dealbata Flowers. Recovery of Bioactive Extracts for Cosmetic Purposes. J. Clean. Prod. 2020, 274, 123143. [Google Scholar] [CrossRef]
- Ibănescu, C.; Danu, M.; Nanu, A.; Lungu, M.; Simionescu, B.C. Stability of Disperse Systems Estimated Using Rheological Oscillatory Shear Tests. Rev. Roum. Chim 2010, 55, 933–940. [Google Scholar]
- Turcov, D.; Barna, A.S.; Blaga, A.C.; Ibanescu, C.; Danu, M.; Trifan, A.; Zbranca, A.; Suteu, D. Dermatocosmetic Emulsions Based on Resveratrol, Ferulic Acid and Saffron (Crocus sativus) Extract to Combat Skin Oxidative Stress-Trigger Factor of Some Potential Malignant Effects: Stability Studies and Rheological Properties. Pharmaceutics 2022, 14, 2376. [Google Scholar] [CrossRef]
- Adejokun, D.A.; Dodou, K. Quantitative Sensory Interpretation of Rheological Parameters of a Cream Formulation. Cosmetics 2020, 7, 2. [Google Scholar] [CrossRef]
- Mieles-Gómez, L.; Lastra-Ripoll, S.E.; Torregroza-Fuentes, E.; Quintana, S.E.; García-Zapateiro, L.A. Rheological and Microstructural Properties of Oil-in-Water Emulsion Gels Containing Natural Plant Extracts Stabilized with Carboxymethyl Cellulose/Mango (Mangifera indica) Starch. Fluids 2021, 6, 312. [Google Scholar] [CrossRef]
- Irato, P.; Santovito, G. Enzymatic and Non-Enzymatic Molecules with Antioxidant Function. Antioxidants 2021, 10, 579. [Google Scholar] [CrossRef]
- Vilela, F.M.P.; Oliveira, F.M.; Vicentini, F.T.M.C.; Casagrande, R.; Verri, W.A.; Cunha, T.M.; Fonseca, M.J.V. Commercial Sunscreen Formulations: UVB Irradiation Stability and Effect on UVB Irradiation-Induced Skin Oxidative Stress and Inflammation. J. Photochem. Photobiol. B 2016, 163, 413–420. [Google Scholar] [CrossRef]
- Wu, Y.; Matsui, M.S.; Chen, J.Z.S.; Jin, X.; Shu, C.M.; Jin, G.Y.; Dong, G.H.; Wang, Y.K.; Gao, X.H.; Chen, H.D.; et al. Antioxidants Add Protection to a Broad-Spectrum Sunscreen. Clin. Exp. Dermatol. 2011, 36, 178–187. [Google Scholar] [CrossRef] [PubMed]
- Ferreira, S.M.; Falé, Z.; Santos, L. Sustainability in Skin Care: Incorporation of Avocado Peel Extracts in Topical Formulations. Molecules 2022, 27, 1782. [Google Scholar] [CrossRef] [PubMed]
- Karioti, A.; Furlan, C.; Vincieri, F.F.; Bilia, A.R. Analysis of the Constituents and Quality Control of Viola Odorata Aqueous Preparations by HPLC-DAD and HPLC-ESI-MS. Anal. Bioanal. Chem. 2011, 399, 1715–1723. [Google Scholar] [CrossRef] [PubMed]
- Nostro, A.; Cannatelli, M.A.; Morelli, I.; Cioni, P.L.; Bader, A.; Marino, A.; Alonzo, V. Preservative Properties of Calamintha Officinalis Essential Oil with and without EDTA. Lett. Appl. Microbiol. 2002, 35, 385–389. [Google Scholar] [CrossRef]
- Boukhira, S.; Balouiri, M.; El Mansouri, L.; El Youbi, A.E.H.; Bouarfa, M.; Lebtar, S.; Ouhammou, A.; Bousta, D. Development of Natural Preservative from Silene Vulgaris Extract in Topical Formulation under a Challenge Test and Its Stability Study. J. Appl. Pharm. Sci. 2017, 7, 142–148. [Google Scholar] [CrossRef]
- de Melo, R.S.; Reis, S.A.G.B.; Guimarães, A.L.; Silva, N.D.D.S.; Rocha, J.M.; El Aouad, N.; Almeida, J.R.G. da S. Phytocosmetic Emulsion Containing Extract of Morus nigra L. (Moraceae): Development, Stability Study, Antioxidant and Antibacterial Activities. Cosmetics 2022, 9, 39. [Google Scholar] [CrossRef]
- Verma, A.; Zanoletti, A.; Kareem, K.Y.; Adelodun, B.; Kumar, P.; Ajibade, F.O.; Silva, L.F.O.; Phillips, A.J.; Kartheeswaran, T.; Bontempi, E.; et al. Skin Protection from Solar Ultraviolet Radiation Using Natural Compounds: A Review. Environ. Chem. Lett. 2024, 22, 273–295. [Google Scholar] [CrossRef]
- Couteau, C.; Coiffard, L. About Suncare Products. In Chemistry Research Summaries; Nova Science Publisher Inc.: Hauppauge, NY, USA, 2016; Volume 2, pp. 45–47. ISBN 9781622576623. [Google Scholar]
- Hübner, A.A.; Sarruf, F.D.; Oliveira, C.A.; Neto, A.V.; Fischer, D.C.H.; Kato, E.T.M.; Lourenço, F.R.; Baby, A.R.; Bacchi, E.M. Safety and Photoprotective Efficacy of a Sunscreen System Based on Grape Pomace (Vitis vinifera L.) Phenolics from Winemaking. Pharmaceutics 2020, 12, 1148. [Google Scholar] [CrossRef]
- Morocho-Jácome, A.L.; Freire, T.B.; de Oliveira, A.C.; de Almeida, T.S.; Rosado, C.; Velasco, M.V.R.; Baby, A.R. In Vivo SPF from Multifunctional Sunscreen Systems Developed with Natural Compounds—A Review. J. Cosmet. Dermatol. 2021, 20, 729–737. [Google Scholar] [CrossRef]
Disclaimer/Publisher’s Note: The statements, opinions and data contained in all publications are solely those of the individual author(s) and contributor(s) and not of MDPI and/or the editor(s). MDPI and/or the editor(s) disclaim responsibility for any injury to people or property resulting from any ideas, methods, instructions or products referred to in the content. |
© 2025 by the authors. Licensee MDPI, Basel, Switzerland. This article is an open access article distributed under the terms and conditions of the Creative Commons Attribution (CC BY) license (https://creativecommons.org/licenses/by/4.0/).















